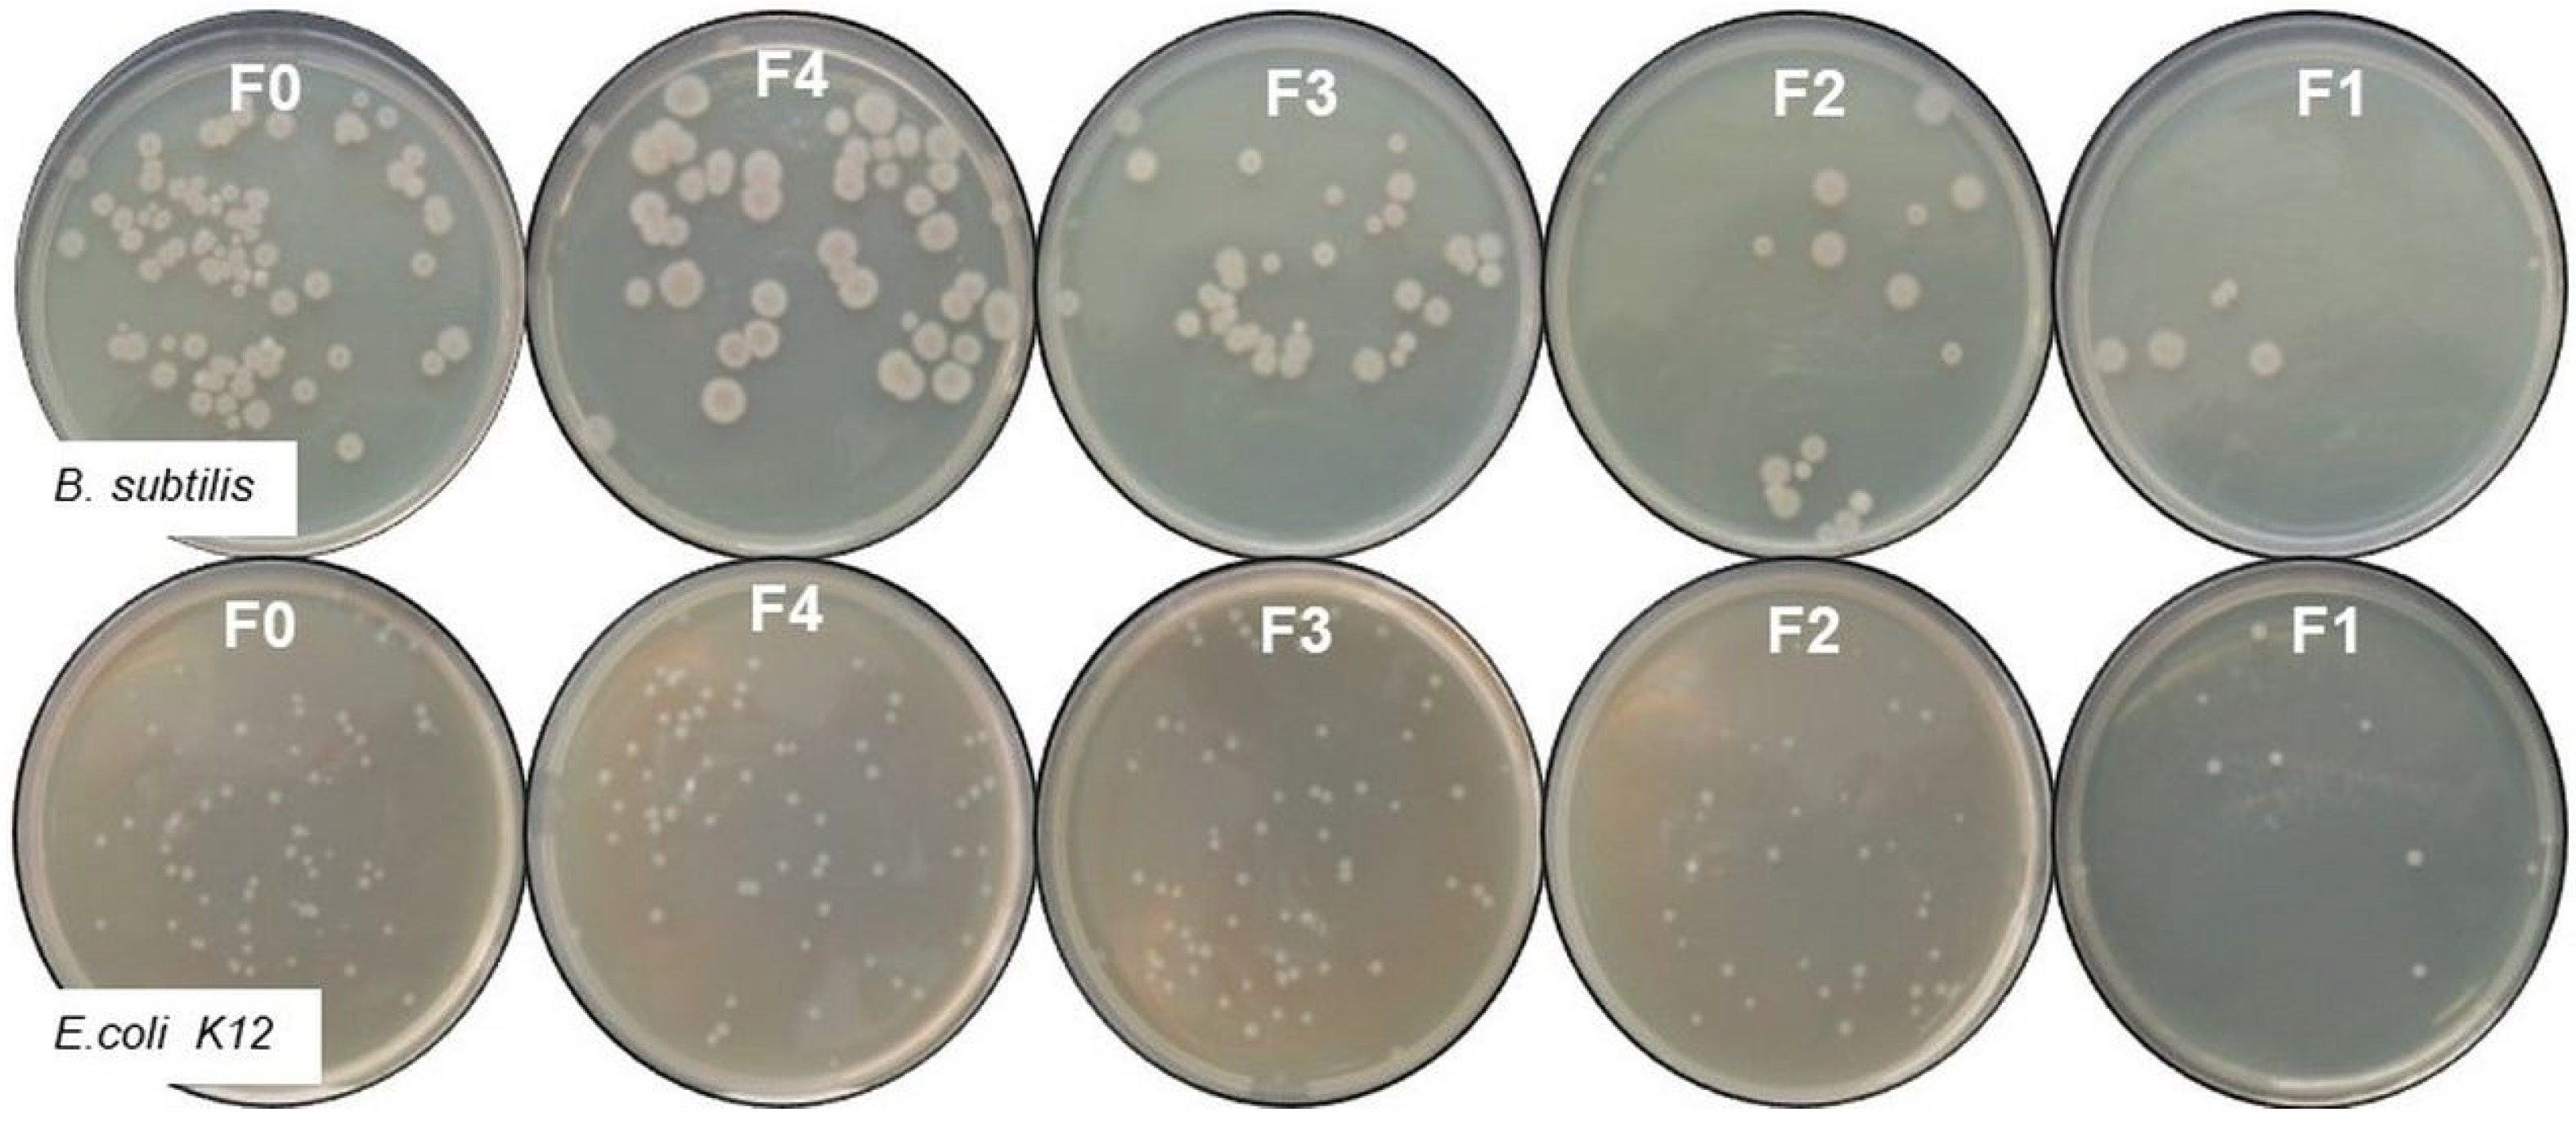
Materials 16 06936 g007

Preparation, Characterization, and Antibacterial Properties of Cu-Fibreboards
Abstract
:1. Introduction
2. Materials and Methods
2.1. Material and Fibreboards Preparation
2.2. Physical and Mechanical Characterizations of the Fibreboards
2.3. Structural and Morphological Characterizations of the Fibreboards
2.4. Antibacterial Activity of the Fibreboards
3. Results and Discussion
4. Conclusions
Author Contributions
Funding
Institutional Review Board Statement
Informed Consent Statement
Data Availability Statement
Conflicts of Interest
References
- Dragnevska, M.; Velev, P.; Nenkova, S.; Garvanska, R. Development of a continuous method for production of copper-sulphide wood-polymer plate nanocomposite materials. J. Univ. Chem. Technol. Metall. 2011, 46, 349–356. [Google Scholar]
- Yotov, N.; Valchev, I.; Petrin, S.; Savov, V. Lignosulphonate and waste technical hydrolysis lignin as adhesives for eco-friendly fiberboard. Bul. Chem. Commun. 2017, 49, 92–97. [Google Scholar]
- Theng, D.; Arbat, G.; Delgado-Aguilar, M.; Vilaseca, F.; Ngo, B.; Mutjé, P. All-lignocellulosic fiberboard from corn biomass and cellulose nanofibers. Ind. Crops Prod. 2015, 76, 166–173. [Google Scholar] [CrossRef]
- Akhtarq, M.; Kenealy, W.R.; Hom, E.G.; Swaney, R.S.; Winandy, J. Metod of Making Medium Density Faberboard. U.S. Patent 2008/0264588 A1, 30 October 2008. [Google Scholar]
- Grzegorzewska, E.; Sedliačiková, M.; Drábek, J.; Behún, M. Evaluating the international competitiveness of polish furniture manufacturing industry in comparison to the selected EU countries. Acta Fac. Xylologiae 2020, 62, 149–164. [Google Scholar] [CrossRef]
- Gul, W.; Alrobei, H. Effect of Graphene Oxide Nanoparticles on the Physical and Mechanical Properties of Medium Density Fiberboard. Polymers 2021, 13, 1818. [Google Scholar] [CrossRef]
- Available online: http://welde.bg/index.php?m=593&lang=2 (accessed on 8 September 2023).
- Available online: https://unece.org/forestrytimber/documents/2022/12/post-session-documents/market-forecast-tables-2022 (accessed on 24 October 2023).
- Antov, P.; Jivkov, V.; Savov, V.; Simeonova, R.; Yavorov, N. Structural Application of Eco-Friendly Composites from Recycled Wood Fibres Bonded with Magnesium Lignosulfonate. Appl. Sci. 2020, 10, 7526. [Google Scholar] [CrossRef]
- Alabduljabbar, H.; Alyousef, R.; Gul, W.; Akbar Shah, S.R.; Khan, A.; Khan, R.; Alaskar, A. Efect of Alumina Nano-Particles on Physical and Mechanical Properties of Medium Density Fiberboard. Materials 2020, 13, 4207. [Google Scholar] [CrossRef]
- Valchev, I.; Yordanov, Y.; Savov, V.; Antov, P. Optimization of the hot-pressing regime in the production of eco-friendly fibreboards bonded with hydrolysis lignin. Periodica Polytech. Chem. Eng. 2022, 66, 125–134. [Google Scholar] [CrossRef]
- Savov, V.; Valchev, I.; Antov, P.; Yordanov, Y.; Popski, Z. Effect of the Adhesive System on the Properties of Fiberboard Panels Bonded with Hydrolysis Lignin and Phenol-Formaldehyde Resin. Polymers 2022, 14, 1768. [Google Scholar] [CrossRef]
- Silva, A.P.S.; Ferreira, B.S.; Favarim, H.R.; Silva, M.F.F.; Silva, J.V.F.; Azambuja, M.A.; Campos, C.I. Physical Properties of Medium Density Fiberboard Produced with the Addition of ZnO Nanoparticles. BioResources 2019, 14, 1618–1625. [Google Scholar] [CrossRef]
- Gul, W.; Alrobei, H.; Akbar Shah, S.R.; Khan, A.; Hussain, A.; Asiri, A.M.; Kim, J. Effect of Embedment of MWCNTs for Enhancement of Physical and Mechanical Performance of Medium Density Fiberboard. Nanomaterials 2021, 11, 29. [Google Scholar] [CrossRef] [PubMed]
- Gul, W.; Alrobei, H.; Akbar Shah, S.R.; Khan, A. Effect of Iron Oxide Nanoparticles on the Physical Properties of Medium Density Fiberboard. Polymers 2020, 12, 2911. [Google Scholar] [CrossRef]
- Gul, W.; Akbar Shah, S.R.; Khan, A.; Ahmad, N.; Ahmed, S.; Ain, N.; Mehmood, A.; Salah, B.; Ullah, S.S.; Khan, R. Synthesis of graphene oxide (GO) and reduced graphene oxide (rGO) and their application as nano-fillers to improve the physical and mechanical properties of medium density fiberboard. Front. Mater. 2023, 10, 1206918. [Google Scholar] [CrossRef]
- Jasmani, L.; Rusli, R.; Khadiran, T.; Jalil, R.; Adnan, S. Application of Nanotechnology in Wood-Based Products Industry: A Review. Nanoscale Res. Lett. 2020, 15, 207. [Google Scholar] [CrossRef]
- Kandelbauer, A.; Widsten, P. Antibacterial melamine resin surfaces for wood-based furniture and flooring. Prog. Org. Coat. 2009, 65, 305–313. [Google Scholar] [CrossRef]
- Nosál, E.; Reinprecht, L. Anti-bacterial and Anti-mold Efficiency of ZnO Nanoparticles Present in Melamine-laminated Surfaces of Particleboards. BioResources 2017, 12, 7255–7267. [Google Scholar] [CrossRef]
- Rangelova, N.; Nenkova, S.; Lazarova, N.; Georgieva, N. Copper-based nanostructured lignocellulose materials with antibacterial activity. Bul. Chem. Commun. 2015, 47, 9–44. [Google Scholar]
- Su, C.; Yuan, Q.; Gan, W.; Dai, D.; Huang, J.; Huang, Y. Study on a Composite Fiberboard with Multiple Electromagnetic Shielding Effectiveness. Open Mater. Sci. J. 2012, 6, 44–49. [Google Scholar] [CrossRef]
- Lee, M.; Park, S.B.; Mun, S.P. One-step preparation of visible-light-responsive TiO2 with carbonized medium-density fiberboard for toluene degradation. Wood Sci. Technol. 2020, 54, 349–364. [Google Scholar] [CrossRef]
- Rangelova, N.; Aleksandrov, L.; Angelova, T.; Georgieva, N.; Müller, R. Preparation and characterization of SiO2/CMC/Ag hybrids with antibacterial properties. Carbohydr. Polym. 2014, 101, 1166–1175. [Google Scholar] [CrossRef]
- Paulose, P.I.; Jose, G.; Thomas, V.; Jose, G.; Unnikrishnan, N.V.; Warrier, M.K.R. Spectroscopic studies of Cu2+ ions in sol–gel derived silica matrix. Bull. Mater. Sci. 2002, 25, 69–74. [Google Scholar] [CrossRef]
- Bejarano, J.; Caviedes, P.; Palza, H. Sol–gel synthesis and in vitro bioactivity of copper and zinc-doped silicate bioactive glasses and glass-ceramics. Biomed. Mater. 2015, 10, 025001. [Google Scholar] [CrossRef] [PubMed]
- Montero, D.A.; Arellano, C.; Pardo, M.; Vera, R.; Gálvez, R.; Cifuentes, M.; Berasain, M.A.; Gómez, M.; Ramírez, C.; Vida, R.M. Antimicrobial properties of a novel copper-based composite coating with potential for use in healthcare facilities. Antimicrob. Resist. Infect. Control 2019, 8, 3. [Google Scholar] [CrossRef]
- Sifri, C.D.; Burke, G.H.; Enfield, K.B. Reduced health care-associated infections in an acute care community hospital using a combination of self-disinfecting copper-impregnated composite hard surfaces and linens. Am. J. Infect. Control 2016, 44, 1565–1571. [Google Scholar] [CrossRef]
- Thukkaram, M.; Vaidulych, M.; Kylian, O.; Rigole, P.; Aliakbarshirazi, S.; Asadian, M.; Nikiforov, A.; Biederman, H.; Coenye, T.; Du Laing, G.; et al. Biological activity and antimicrobial property of Cu/aC: H nanocomposites and nanolayered coatings on titanium substrates. Mat. Sci. Eng. C 2021, 119, 111513. [Google Scholar] [CrossRef]
- Zhang, J.; Li, J.; Zhang, Q.; Guo, D. Constructing a novel CuS/Cu2S Z-scheme heterojunction for highly-efficiency NIR light-driven antibacterial activity. Appl. Surf. Sci. 2023, 624, 156848. [Google Scholar] [CrossRef]
- Nenkova, S.; Velev, P.; Dragnevska, M.; Nikolova, D.; Dimitrov, K. Lignocellulose nanocomposite containing copper sulfide. BioResources 2011, 6, 2356–2365. [Google Scholar] [CrossRef]
- BDS EN 310:1999; Wood-Based Panels—Determination of Modulus of Elasticity in Bending and of Bending Strength. BDS: Sofia, Bulgaria, 1999.
- BDS EN 317:1998; Particleboards and Fiberboards—Determination of Swelling in Thickness after Immersion in Water. BDS: Sofia, Bulgaria, 1998.
- BDS EN 324-1:2001; Wood-Based Panels—Determination of Dimensions of Boards—Part 1: Determination of Thickness, Width and Length. BDS: Sofia, Bulgaria, 2001.
- BDS EN 622-1:2004; Fibreboards—Specifications—Part 1: General Requirements. BDS: Sofia, Bulgaria, 2004.
- BDS EN 622-2:2004; Fibreboards—Specifications—Part 2: Requirements for Hardboards. BDS: Sofia, Bulgaria, 2004.
- Taghiyari, H.R.; Bayani, S.; Militz, H.; Papadopoulos, A.N. Heat treatment of pine wood: Possible effect of impregnation with silver nanosuspension. Forests 2020, 11, 466. [Google Scholar] [CrossRef]
- Labidi, K.; Korhonen, O.; Zrida, M.; Hamzaoui, A.H.; Budtova, T. All-cellulose composites from alfa and wood fibers. Ind. Crops Prod. 2019, 127, 135–141. [Google Scholar] [CrossRef]
- Chen, W.; Yu, H.; Liu, Y.; Chen, P.; Zhang, M.; Haib, Y. Individualization of cellulose nanofibers from wood using high-intensity ultrasonication combined with chemical pretreatments. Carbohydr. Polym. 2011, 83, 1804–1811. [Google Scholar] [CrossRef]
- Das, D.; Hussain, S.; Ghosh, A.K.; Pal, A.K. Studies on cellulose nanocrystals extracted from musa sapientum: Structural and bonding aspects. Cellul. Chem. Technol. 2018, 52, 729–739. [Google Scholar]
- Holy, S.; Temiz, A.; Demirel, G.K.; Aslan, M.; Amini, M.H.M. Physical properties, thermal and fungal resistance of Scots pine wood treated with nano-clay and several metal-oxides nanoparticles. Wood Mater. Sci. Eng. 2022, 17, 176–185. [Google Scholar] [CrossRef]
- Sulaiman, N.S.; Hashim, R.; Hiziroglu, S.; Amini, M.H.M.; Sulaiman, O.; Selamat, M.E. Rubberwood particleboard manufactured using epichlorohydrin-modified rice starch as a binder. Cellul. Chem. Technol. 2016, 50, 329–338. [Google Scholar]
- Boon, J.G.; Hashim, R.; Sulaiman, O.; Sugimoto, T.; Sato, M.; Salim, N.; Amini, M.H.M.; Ibrahım, N.I.; Ramle, S.F.M. Importance of lignin on the properties of binderless particleboard made from oil palm trunk. ARPN J. Eng. Appl. Sci. 2017, 12, 33–40. [Google Scholar]
- Carrier, M.; Loppinet-Serani, A.; Denux, D.; Lasnier, J.-M.; Ham-Pichavant, F.; Cansell, F.; Aymonier, C. Thermogravimetric analysis as a new method to determine the lignocellulosic composition of biomass. Biomass Bioenergy 2011, 35, 298–307. [Google Scholar] [CrossRef]
- Ramyadevi, J.; Jeyasubramanian, K.; Marikani, A.; Rajakumar, G.; Rahuman, A.A. Synthesis and antimicrobial activity of copper nanoparticles. Mater. Lett. 2012, 71, 114–116. [Google Scholar] [CrossRef]
- Grace, M.; Chand, N.; Bajpai, S. Copper Alginate-Cotton Cellulose (CACC) Fibers with Excellent Antibacterial Properties. J. Eng. Fibers Fabr. 2009, 4, 24–35. [Google Scholar] [CrossRef]
- Raffi, M.; Mehrwan, S.; Bhatti, T.M.; Akhter, J.I.; Hameed, A.; Yawar, W.; Masood ul Hasan, M. Investigations into the antibacterial behavior of copper nanoparticles against Escherichia coli. Ann. Microbiol. 2010, 60, 75–80. [Google Scholar] [CrossRef]
- Kartal, S.N.; Green, I.F.; Clausen, C.A. Do the unique properties of nanometals affect leachability or efficacy against fungi and termites? Int. Biodeterior. Biodegrad. 2009, 63, 490–495. [Google Scholar] [CrossRef]
- Bagchi, B.; Kar, S.; Dey, S.K.; Bhandary, S.; Roy, D.; Mukhopadhyay, T.K.; Dasa, S.; Nandy, P. In situ synthesis and antibacterial activity of copper nanoparticle loaded natural montmorillonite clay based on contact inhibition and ion release. Colloids Surf. B. 2013, 108, 358–365. [Google Scholar] [CrossRef]
- Ma, X.; Zhou, S.; Xu, X.; Du, Q. Copper containing nanoparticles: Mechanism of antimicrobial effect and application in dentistry-a narrative review. Front. Surg. 2022, 9, 905892. [Google Scholar] [CrossRef] [PubMed]

| Fibreboards | Conditions 45% Reagents to WF and 170 °C | Copper Content in Samples, % | Physical and Mechanical Properties | ||
|---|---|---|---|---|---|
| Thickness, mm | Bending Strength, MPa | Swelling, % | |||
| F0 | - | 0.01 | 2.8 | 49.78 | 34.48 |
| F1 | ratio 1:1; 17 min | 1.07 | 3.0 | 33.30 | 19.35 |
| F2 | ratio 1:1.5; 12 min | 0.76 | 2.9 | 41.62 | 25.92 |
| F3 | ratio 1:2; 7 min | 0.36 | 2.8 | 44.01 | 32 |
| F4 | ratio 1:2; 17 min | 0.40 | 2.9 | 40.84 | 34.61 |
| Sample | B. subtilis | E. coli | ||||
|---|---|---|---|---|---|---|
| CFU/mL | Inhibition, % | Copper Release, mg/L | CFU/ mL | Inhibition, % | Copper Release, mg/L | |
| F0 | 68 × 108 | 0 | 0.044 | 2.6 × 1010 | 0 | 0.027 |
| F1 | 20.1 × 108 | 70.5 | 12.67 | 0.4 × 1010 | 84.6 | 11.9 |
| F2 | 35 × 108 | 48.5 | 8.909 | 0.6 × 1010 | 77 | 8.093 |
| F3 | 47.2 × 108 | 31 | 2.050 | 1.6 × 1010 | 38.5 | 1.769 |
| F4 | 39.2 × 108 | 42.4 | 2.80 | 1.6 × 1010 | 38.5 | 3.797 |
Disclaimer/Publisher’s Note: The statements, opinions and data contained in all publications are solely those of the individual author(s) and contributor(s) and not of MDPI and/or the editor(s). MDPI and/or the editor(s) disclaim responsibility for any injury to people or property resulting from any ideas, methods, instructions or products referred to in the content. |
© 2023 by the authors. Licensee MDPI, Basel, Switzerland. This article is an open access article distributed under the terms and conditions of the Creative Commons Attribution (CC BY) license (https://creativecommons.org/licenses/by/4.0/).
Share and Cite
Aleksandrov, L.; Rangelova, N.; Lazarova-Zdravkova, N.; Georgieva, N.; Dragnevska, M.; Nenkova, S. Preparation, Characterization, and Antibacterial Properties of Cu-Fibreboards. Materials 2023, 16, 6936. https://doi.org/10.3390/ma16216936
Aleksandrov L, Rangelova N, Lazarova-Zdravkova N, Georgieva N, Dragnevska M, Nenkova S. Preparation, Characterization, and Antibacterial Properties of Cu-Fibreboards. Materials. 2023; 16(21):6936. https://doi.org/10.3390/ma16216936
Chicago/Turabian StyleAleksandrov, Lyubomir, Nadezhda Rangelova, Nevena Lazarova-Zdravkova, Nelly Georgieva, Mirela Dragnevska, and Sanchi Nenkova. 2023. "Preparation, Characterization, and Antibacterial Properties of Cu-Fibreboards" Materials 16, no. 21: 6936. https://doi.org/10.3390/ma16216936
APA StyleAleksandrov, L., Rangelova, N., Lazarova-Zdravkova, N., Georgieva, N., Dragnevska, M., & Nenkova, S. (2023). Preparation, Characterization, and Antibacterial Properties of Cu-Fibreboards. Materials, 16(21), 6936. https://doi.org/10.3390/ma16216936

